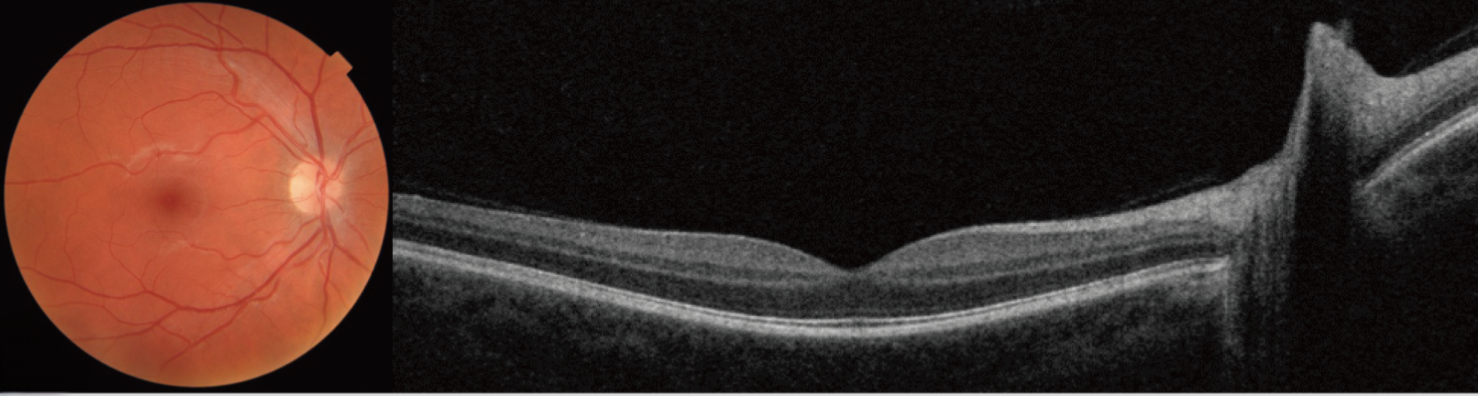

Comprehensive Eye Care
A Comprehensive Eye Exam: More Than Just an Updated Prescription!
Regular comprehensive eye exams are essential for maintaining optimal eye health. They not only help monitor your vision and provide updated prescriptions, but also play a crucial role in diagnosing, treating, and managing common eye and vision conditions.
These exams involve a series of routine tests, including eye dilation, recommendations for contact lenses, a personalized dry eye care regimen, or close monitoring and management of other conditions like cataracts, glaucoma and diabetic retinopathy.
What To Expect
What to Expect During Your Comprehensive Eye Exam:
A detailed case history about your lifestyle, family and medical history, and current medications
An examination utilizing advanced technology to screen for and manage eye conditions
Tests May Include
Visual Acuity and Refraction
Eye Pressure Test
Peripheral Vision Assessment
Visual Field Testing
Digital Retinal Imaging
Binocular Vision Assessment
OCT Scan (Optical Coherence Tomography)
Colour Vision Testing
Further testing
Equipped with advanced diagnostic technology, including medical imaging and scans, to accurately diagnose, treat, and manage ocular diseases.
Visual Field Testing
A Key Tool for Detecting Changes in Peripheral Vision
Visual field testing is a vital diagnostic procedure that evaluates how much of your surrounding environment you can see without moving your eyes- known as peripheral vision. This test maps the full horizontal and vertical range of your vision and helps identify any areas where your sight may be reduced or missing, known as blind spots.
It plays a crucial role in the early detection and management of several serious conditions, including:
Glaucoma
Optic nerve damage
Neurological disorders (such as strokes or brain tumors)
Retinal diseases
During the test, you’ll be asked to focus on a central point while responding to lights or patterns that appear in your side vision. The results help your eye care provider determine if there are any irregularities and monitor for changes over time.
Results are printed immediately and securely saved to your record, allowing for ongoing monitoring and more informed treatment decisions.
Optical Coherence Tomography (OCT)
What is Optical Coherence Tomography (OCT)?
OCT is a state-of-the-art, non-invasive imaging technology that provides high-resolution, cross-sectional images of the retina, cornea, and optic nerve.
This painless scan allows your Optometrist to see the individual layers of the eye in remarkable detail - offering a level of insight that isn’t possible with standard eye exams.
OCT is especially valuable for detecting early signs of eye conditions such as:
Glaucoma
Age-related macular degeneration (AMD)
Diabetic retinopathy
Retinal swelling or thinning
By identifying even the subtlest changes, OCT plays a critical role in diagnosing, monitoring, and guiding treatment decisions - helping protect your vision for the long term.